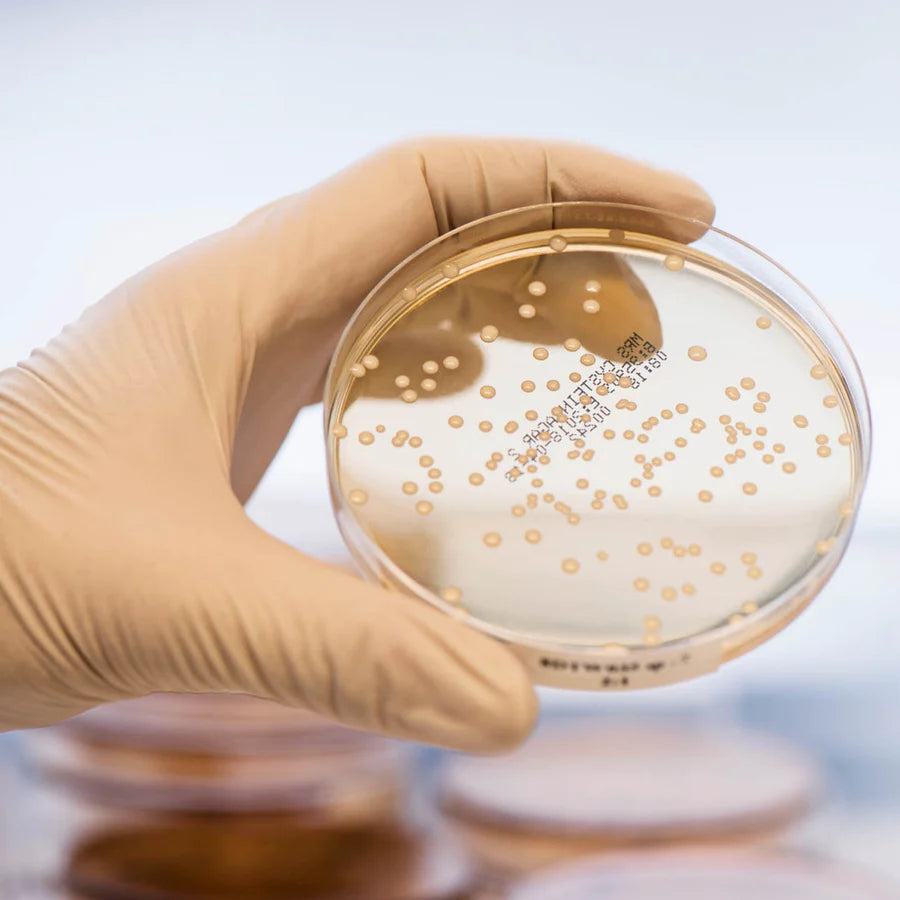

BioGaia Prodentis KIDS
Kosttillskott med probiotika, innehåller sötningsmedel. 30 sugtabletter.
BioGaia Prodentis KIDS är ett avancerat probiotiskt kosttillskott för munnen* med fräsch äpplesmak. Innehåller två patenterade bakteriestammar av hög kvalitet som hjälper till att balansera den orala bakteriefloran.
Varför välja den här produkten?
Världens mest studerade probiotika** för munnen
Två patenterade bakteriestammar
För god mun/tandhälsa samt fräsch andedräkt
Säker för långvarig daglig användning
BioGaia Prodentis KIDS innehåller de patenterade mjölksyrabakterierna L. reuteri DSM 17938 och L. reuteri ATCC PTA 5289*** som trivs på munnens slemhinnor.
L. reuteri Prodentis har testats i mer än 50 kliniska studier.
• En tablett innehåller 200 miljoner levande L. reuteri Prodentis
• Innehåller två unika patenterade bakteriestammar
• Säker för långvarig användning
- Fri från mjölk, laktos och gluten
- Sugtabletter med äpplesmak
* Konsumtion av livsmedel som innehåller isomalt och xylitol istället för sockerarter bidrar till att bibehålla tändernas mineralisering.
** Enligt antalet publicerade artiklar på Pubmed (juli 2021).
*** Limosilactobacillus reuteri (tidigare känd som Lactobacillus reuteri).
Kosttillskott med sötningsmedel, 30 sugtabletter med mjölksyrabakterierna L. reuteri DSM 17938 och L. reuteri ATCC PTA 5289. En sugtablett innehåller minst 200 miljoner CFU (antal levande bakterier) L. reuteri Prodentis. Två sugtabletter innehåller minst 400 miljoner CFU (antal levande bakterier) L. reuteri Prodentis.
Mjölksyrabakterier, 30 sugtabletter med L. reuteri DSM 17938 och L. reuteri ATCC PTA 5289, äpplesmak.
Förvaring: Förvaras på en torr plats som inte överstiger rumstemperatur (max 25°C).
Förvaras oåtkomligt för små barn.
Ingredienser: Fyllnadsmedel (isomalt), sötningsmedel (xylitol), aromer, L. reuteri DSM 17938 och L. reuteri ATCC PTA 5289 och smakförstärkare (citronsyra).
Rekommenderad daglig dos:1-2 sugtabletter. Rekommenderad daglig dos bör inte överskridas. Överdriven konsumtion kan ha laxerande effekt.
Från 3 år. Låt sugtabletten smälta i munnen. Använd regelbundet som ett komplement till den dagliga rutinen för munvård, med fördel efter tandborstning.
Kosttillskott bör inte användas som ett alternativ till varierad kost. Det är också viktigt med en hälsosam livsstil.
För optimal tarmhälsa
BioGaia Prodentis KIDS är ett avancerat kosttillskott med probiotika för munnen* i form av goda sugtabletter med fräsch äpplesmak.

Mer än 200 000 timmars probiotisk forskning
Folk kanske kallar oss galna för att vi spenderat över 30 år på att forska, analysera, testa och analysera bakteriestammar igen. Men vi älskar vetenskap. Det är vad vi gör. Bakom våra produkter hittar du över 200 000 timmar av probiotisk forskning.